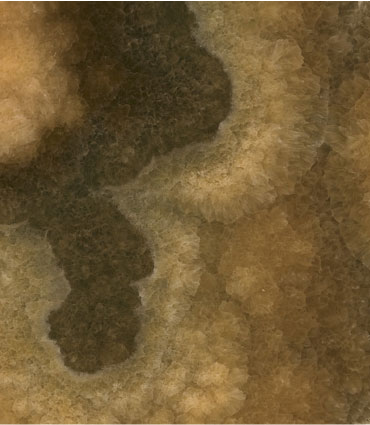

Onice Cappuccino
Артикул
ART00386
Фабрика камня ARTISHOCK® - одно из наиболее современных и технически оснащенных камнеобрабатывающих производств московского региона.
 Посмотреть видео
Посмотреть видео
ARTISHOCK® работает с камнем уже более 17 лет. Производство располагает новейшими распиловочными станками с ЧПУ итальянского производства. Оборудование позволяет выпускать не только столешницы и подоконники, но и малые архитектурные формы, мозаики и мозаичные панно. Специалисты фабрики тщательно следят за последними тенденциями развития рынка природного камня и уделяют особое внимание составлению актуальной коллекции различных материалов с широкой географией происхождения.
Материал: мрамор
Страна производитель: Иран
Фабрика камня ARTISHOCK® - одно из наиболее современных и технически оснащенных камнеобрабатывающих производств московского региона. ARTISHOCK® работает с камнем уже более 17 лет. Производство располагает новейшими распиловочными станками с ЧПУ итальянского производства. Оборудование позволяет выпускать не только столешницы и подоконники, но и малые архитектурные формы, мозаики и мозаичные панно. Специалисты фабрики тщательно следят за последними тенденциями развития рынка природного камня и уделяют особое внимание составлению актуальной коллекции различных материалов с широкой географией происхождения.